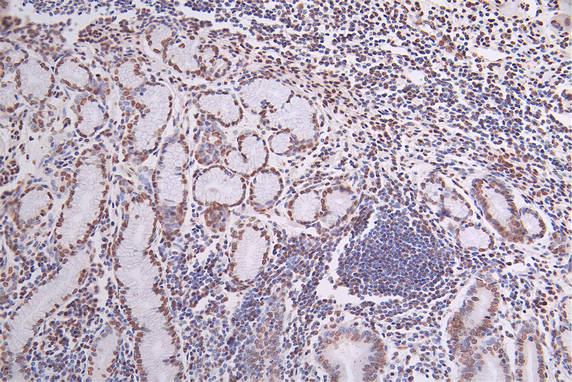

H2AFX Recombinant Monoclonal Antibody
-
中文名稱:H2AFX重組抗體
-
貨號:CSB-RA034362A0HU
-
規(guī)格:¥1320
-
圖片:
-
IHC image of CSB-RA034362A0HU diluted at 1:50 and staining in paraffin-embedded human pancreati tissue performed on a Leica BondTM system. After dewaxing and hydration, antigen retrieval was mediated by high pressure in a citrate buffer (pH 6.0). Section was blocked with 10% normal goat serum 30min at RT. Then primary antibody (1% BSA) was incubated at 4°C overnight. The primary is detected by a Goat anti-rabbit polymer IgG labeled by HRP and visualized using 0.27% DAB.
-
IHC image of CSB-RA034362A0HU diluted at 1:50 and staining in paraffin-embedded human breast cancer performed on a Leica BondTM system. After dewaxing and hydration, antigen retrieval was mediated by high pressure in a citrate buffer (pH 6.0). Section was blocked with 10% normal goat serum 30min at RT. Then primary antibody (1% BSA) was incubated at 4°C overnight. The primary is detected by a Goat anti-rabbit polymer IgG labeled by HRP and visualized using 0.27% DAB.
-
Overlay Peak curve showing HepG2 cells stained with CSB-RA034362A0HU (red line) at 1:50. The cells were fixed in 4% formaldehyde and permeated by 0.2% TritonX-100. Then 10% normal goat serum to block non-specific protein-protein interactions followed by the antibody (1μg/1*106cells) for 45min at 4℃. The secondary antibody used was FITC-conjugated Goat Anti-rabbit IgG(H+L) at 1:200 dilution for 35min at 4℃.Control antibody (green line) was rabbit IgG (1μg/1*106cells) used under the same conditions. Acquisition of >10,000 events was performed.
-
-
其他:
產(chǎn)品詳情
-
產(chǎn)品描述:CSB-RA034362A0HU H2AFX重組單克隆抗體是針對組蛋白H2A家族成員X(H2AFX)研發(fā)的高特異性檢測工具。H2AFX作為DNA損傷應(yīng)答的核心調(diào)控因子,其磷酸化形式(γ-H2AFX)是雙鏈斷裂修復(fù)的重要分子標(biāo)記,在基因組穩(wěn)定性維持和細(xì)胞周期調(diào)控中發(fā)揮關(guān)鍵作用。本產(chǎn)品經(jīng)過ELISA、免疫組化(IHC)和流式細(xì)胞術(shù)(FC)多平臺驗證,在推薦稀釋比例范圍內(nèi)(IHC 1:50-1:200,F(xiàn)C 1:50-1:200)展現(xiàn)出優(yōu)異的抗原結(jié)合能力與低背景特性,可精準(zhǔn)識別內(nèi)源性H2AFX蛋白。適用于體外培養(yǎng)細(xì)胞的DNA損傷模型構(gòu)建、輻射或化學(xué)誘導(dǎo)的基因組應(yīng)激研究,以及腫瘤樣本中DNA修復(fù)活性的組織定位分析。重組單克隆技術(shù)確保抗體批次間高度均一性,為DNA損傷信號通路研究、癌癥發(fā)生機制探索及基因毒性藥物篩選提供穩(wěn)定可靠的檢測方案。
-
Uniprot No.:
-
基因名:
-
別名:Histone H2AX (H2a/x) (Histone H2A.X), H2AFX, H2AX
-
反應(yīng)種屬:Human
-
免疫原:A synthesized peptide derived from Human H2AFX
-
免疫原種屬:Homo sapiens (Human)
-
標(biāo)記方式:Non-conjugated
-
克隆類型:Monoclonal
-
抗體亞型:Rabbit IgG
-
純化方式:Affinity-chromatography
-
克隆號:29H6
-
濃度:It differs from different batches. Please contact us to confirm it.
-
保存緩沖液:Rabbit IgG in 10mM phosphate buffered saline , pH 7.4, 150mM sodium chloride, 0.05% BSA, 0.02% sodium azide and 50% glycerol.
-
產(chǎn)品提供形式:Liquid
-
應(yīng)用范圍:ELISA, IHC, FC
-
推薦稀釋比:
Application Recommended Dilution IHC 1:50-1:200 FC 1:50-1:200 -
Protocols:
-
儲存條件:Upon receipt, store at -20°C or -80°C. Avoid repeated freeze.
-
貨期:Basically, we can dispatch the products out in 1-3 working days after receiving your orders. Delivery time maybe differs from different purchasing way or location, please kindly consult your local distributors for specific delivery time.
-
用途:For Research Use Only. Not for use in diagnostic or therapeutic procedures.
相關(guān)產(chǎn)品
靶點詳情
-
功能:Variant histone H2A which replaces conventional H2A in a subset of nucleosomes. Nucleosomes wrap and compact DNA into chromatin, limiting DNA accessibility to the cellular machineries which require DNA as a template. Histones thereby play a central role in transcription regulation, DNA repair, DNA replication and chromosomal stability. DNA accessibility is regulated via a complex set of post-translational modifications of histones, also called histone code, and nucleosome remodeling. Required for checkpoint-mediated arrest of cell cycle progression in response to low doses of ionizing radiation and for efficient repair of DNA double strand breaks (DSBs) specifically when modified by C-terminal phosphorylation.
-
基因功能參考文獻:
- ZNF506-dependent positive feedback loop regulates H2AX signaling after DNA damage. PMID: 30013081
- This study confirms that H2AFX variants are associated with an increased risk of BC. The above-reported sequence variants of MRE11 genes may not constitute a risk factor of breast cancer in the Polish population. PMID: 29678143
- gamma-irradiation also decreased the number of cells in the G1 phase, characterized by no interaction between H3S10ph and gammaH2AX. PMID: 30096372
- The topology of clusters of gammaH2AX foci can be categorized depending on the distance to heterochromatin. The here presented new method opens up new possibilities to categorize spatial organization of point patterns by parameterization of topological similarity. PMID: 30072594
- this study suggests that individual and co-expression pattern of nuclear oxidized-PTP and gamma-H2AX might be used as a prognostic marker of gastric carcinoma PMID: 30126387
- Low pH2AX expression is associated with mouth Cancer. PMID: 30275188
- Results show that the H2AX 3'U TR is targeted by miR328 and its expression inhibited in osteosarcoma cells under radiation conditions. PMID: 29207178
- The results propose a model in which Aurora B-mediated H2AX-phosphorylated serine 121 probably provide a platform for Aurora B autoactivation circuitry at centromeres and thus play a pivotal role in proper chromosome segregation. PMID: 27389782
- Data indicate that nuclear H2A histone family, member X protein (gammaH2AX) expression is positively associated with the programmed death-ligand 1 (PD-L1) expression in lung squamous cell carcinoma. PMID: 29275316
- phosphorylated histone H2AX was predictive of disease progression epithelial dysplasia of the oral cavity. PMID: 28543539
- Gamma-H2AX, phosphorylated KAP-1 and 53BP1 play an important role in the repair of heterochromatic radon-induced DNA double-strand breaks. PMID: 27922110
- in a series of human biopsies, non-metastatic SCCs displayed a higher degree of chromosomal alterations and higher expression of the S phase regulator Cyclin E and the DNA damage signal gammaH2AX than the less aggressive, non-squamous, basal cell carcinomas. However, metastatic Squamous cell carcinoma lost the gammaH2AX signal and Cyclin E, or accumulated cytoplasmic Cyclin E. PMID: 28661481
- We found that phosphorylation of histone H2AX on Ser139 (gamma-H2AX), a biomarker of DSBs, and phosphorylation of ATM at Ser1981, Chk2 at Thr68, and p53 at Ser15, part of signaling pathways associated with DSBs, are elevated in these cells. PMID: 28388353
- number of gammaH2AX foci did not significantly change following cardiac MR (median foci per cell pre-MR = 0.11, post-MR = 0.11, p = .90), but the number of 53BP1 foci significantly increased following MR PMID: 29309426
- Study provides evidence that phosphorylated H2AX binds to the promoter of miR-3196 and regulate its expression leading to lung cancer cell apoptosis. PMID: 27780918
- there may not be a link between low level phosphorylation gammaH2AX sites and double-strand DNA breaks in cells exposed to topoisomerase I or II inhibitors PMID: 27391338
- Residual gammaH2AX foci induced by low dose x-ray radiation in bone marrow mesenchymal stem cells do not cause accelerated senescence in the progeny of irradiated cells. PMID: 29165316
- miR-24-mediated knockdown of H2AX may be a novel negative regulator of mitochondrial function and insulin signaling. PMID: 28386126
- suggest that pH2AX alone or better in combination with MAP17 may become a novel and valuable prognostic biomarker for patients with laryngeal carcinoma treated with preservation approaches. PMID: 27166270
- The findings demonstrate that RNF168 couples PALB2-dependent homologous recombination to H2A ubiquitylation to promote DNA repair and preserve genome integrity. PMID: 28240985
- Data show that co-treated with vincristine and XL019, a inhibitor of JAK2 and P-glycoprotein (P-gp), up-regulated expression of p21 and phosphorylated H2A histone family, member X (pH2AX). PMID: 29187454
- The bile acid receptor TGR5, inducible nitric oxide synthase (iNOS) and gamma-histone family 2A variant (gamma-H2AX) are up-regulated. PMID: 27247425
- Co-localization of gammaH2AX and 53BP1 indicates promotion of (in)effective nonhomologous end-joining repair mechanisms at sites of DSB. Moreover, gammaH2AX/53BP1 foci distribution presumably reveals a non-random spatial organization of the genome in MDS and AML. PMID: 28359030
- Cyclin F-mediated degradation of SLBP limits H2A.X accumulation and apoptosis upon genotoxic stress in G2 cell cycle checkpoint. PMID: 27773672
- study demonstrates that the individual and combined expression patterns of the DDR molecules PARP1, gammaH2AX, BRCA1, and BRCA2 could be predictive of the prognosis of STS patients and suggests that controlling the activity of these DDR molecules could be employed in new therapeutic stratagems for the treatment of STS PMID: 27643881
- Further analysis suggested that H2AX, a PARP-1 protein interaction partner, was coordinated with PARP-1 in hepatocellular carcinoma tumorigenesis. Overall, some new characteristics of PARP-1 expression were noted in the Zhuang population. PARP-1 is a novel promising diagnostic marker for hepatocellular carcinoma in the Southern Chinese Zhuang population PMID: 28714367
- we found that gamma-H2AX foci at chromosome boundaries after carbon-ion irradiation contain DNA double strand breaks undergoing DNA-end resection, which promotes repair utilizing microhomology mediated end-joining during translocation. PMID: 27113385
- this study demonstrates an early DDR defect of attenuated gammaH2AX signals in G0/G1 phase HGPS cells and provides a plausible connection between H3K9me3 loss and DDR deficiency. PMID: 27907109
- Data indicate an important role for histone H2A.X (H2AX) Tyr39 phosphorylation in gamma-H2A.X formation and cancer progression. PMID: 27813335
- we suggest that the XAB2 complex mediates DNA damage response events important for the end resection step of homologous recombination , and speculate that its adjacent-localization relative to double-strand break marked by gH2AX is important for this function PMID: 27084940
- the epithelial-mesenchymal transition-related transcription factor Twist1 cooperates with Slug to regulate EMT upon H2A.X Loss. PMID: 27315462
- Upon DNA damage, an increase in the levels of chromatin bound motor protein nuclear myosin 1 (NM1) ensues, which appears to be functionally linked to Upsilon-H2AX signaling. PMID: 27365048
- TRAF6 and H2AX overexpression and gammaH2AX-mediated HIF1alpha enrichment in the nucleus of cancer cells lead to overactivation of HIF1alpha-driven tumorigenesis, glycolysis and metastasis. PMID: 27918549
- gammaH2AX, claimed to be a marker of DNA double-strand breaks, was found in cell extracts of HeLa cells at elevated temperature vs. 37.0 degrees C, and these gammaH2AX signals were intensified in the presence of 3-aminobenzamide, a PARP inhibitor. PMID: 27262441
- Data provide evidence that the acetylation of H2AX at Lys5 by TIP60 is required for the (ADPribosyl) ation activity and the dynamic binding of PARP-1 to chromatin after the induction of DNA damage. PMID: 26976643
- data cannot finally exclude H2AX methylation of SUV39H2 in cells, additional experimental evidence is required to validate this claim. PMID: 27177470
- This review outlines the role of gamma-H2AX in cell cycle, and its formation as a result of DNA damage. We investigate the role of gamma-H2AX formation in several cancer types and its correlation with other prognostic factors, and we try to find out whether it fulfills the requirements for its establishment as a classical cancer prognostic factor PMID: 28351323
- this study identified histone H2AX as an antigen of systemic lupus erythematosus by comparing highly ranked genes from all the built network-derived gene lists, which was confirmed the with real-world clinical samples PMID: 27226232
- dyserythropoiesis was increased in MDS patients with the deletion of chromosome 11q23, where H2AX is located. Although loss of H2AX did not affect the early stage of terminal erythropoiesis, enucleation was decreased. PMID: 26791933
- the formation of 53BP1, gammaH2AX foci and their co-localization induced by gamma-rays (2, 5, 10, 50, 200 cGy) in human lymphocytes, was analyzed. PMID: 26243567
- 5-Hydroxymethylcytosine (5hmC) accumulates at DNA damage foci and colocalizes with major DNA damage response proteins 53BP1 and gH2AX, revealing 5hmC as an epigenetic marker of DNA damage. PMID: 26854228
- Anacardic acid sensitizes prostate cancer cells to radiation therapy by repressing H2AX expression. PMID: 26884865
- Results reveal a pathway controlled by ATM, SIRT6, and SNF2H to block HUWE1, which stabilizes H2AX and induces its incorporation into chromatin only when cells are damaged. PMID: 26711340
- Gene expression analysis identified deregulation of histone H2A and H2B genes in all four cell lines ;histone pathways are associated with epirubicin resistance PMID: 26852132
- kinetics of the accumulation of selected DNA repair-related proteins is protein specific at locally induced DNA lesions, and that the formation of gH2AX- and NBS1-positive foci, but not 53BP1-positive NBs, is cell cycle dependent in HeLa cells PMID: 26482424
- The interaction of MDC1 with RNF8, but not with ATM requires WRAP53beta, suggesting that WRAP53beta facilitates the former interaction without altering phosphorylation of MDC1 by ATM. PMID: 26734725
- the interaction of 53BP1 with gammaH2AX is required for sustaining the 53BP1-dependent focal concentration of activated ATM that facilitates repair of DNA double-strand breaks in heterochromatin in G1. PMID: 26628370
- X-rays induce prolonged and ATM-independent persistence of gammaH2AX foci in human gingival mesenchymal stem cells PMID: 26314960
- Cell levels of gammaH2Ax define the G2 phase of the cell cycle. PMID: 26317799
- The study shows higher expression of gamma-H2AX and 53BP1 foci in rectal cancer patients compared with healthy individuals. Yet the data in vitro were not predictive in regard to the radiotherapy outcome. PMID: 26541290
顯示更多
收起更多
-
亞細(xì)胞定位:Nucleus. Chromosome.
-
蛋白家族:Histone H2A family
-
數(shù)據(jù)庫鏈接:
Most popular with customers
-
-
YWHAB Recombinant Monoclonal Antibody
Applications: ELISA, WB, IHC, IF, FC
Species Reactivity: Human, Mouse, Rat
-
Phospho-YAP1 (S127) Recombinant Monoclonal Antibody
Applications: ELISA, WB, IHC
Species Reactivity: Human
-
-
-
-
-